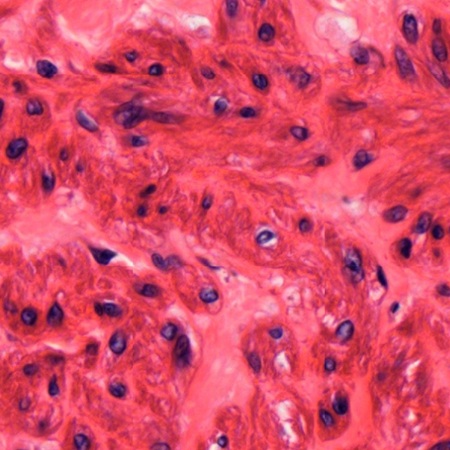
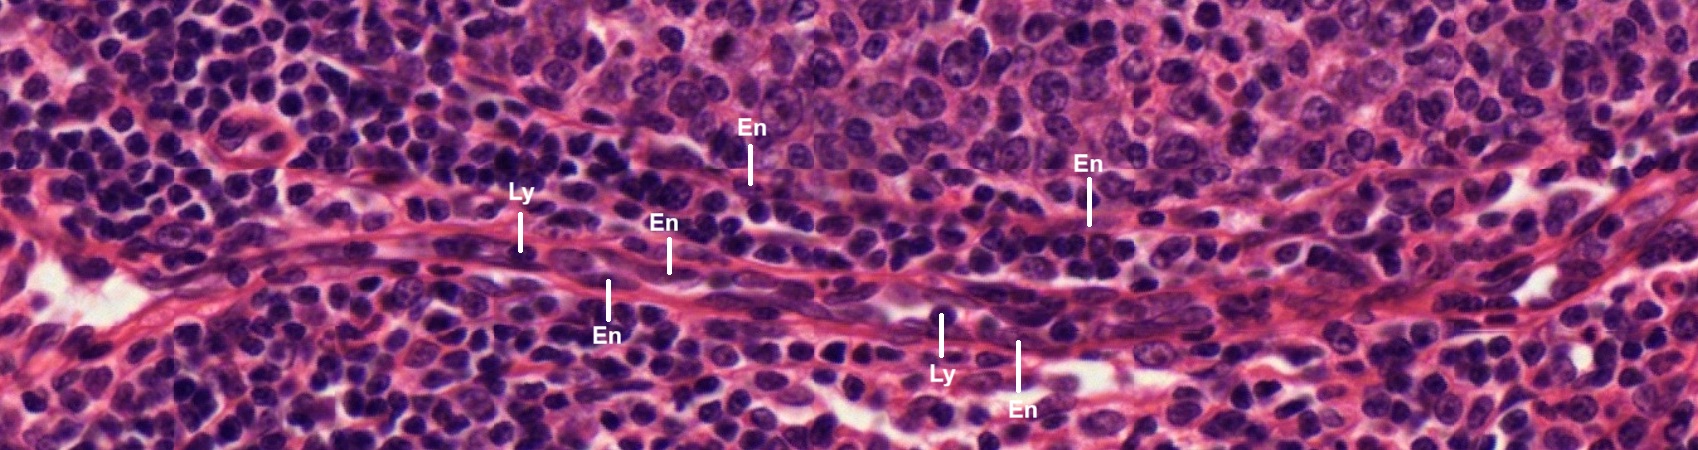
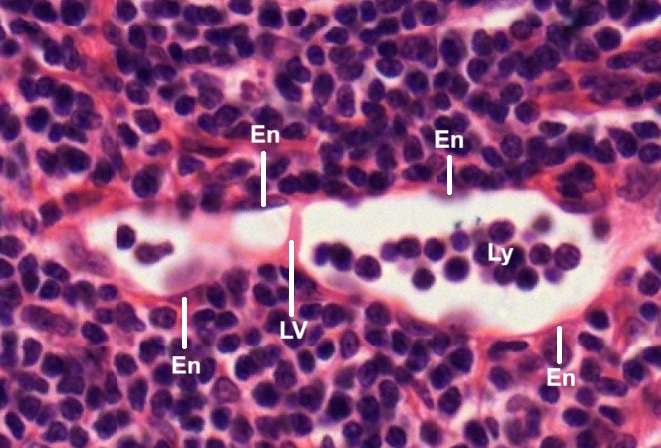

It is also called blood vascular system comprising heart as a pumping organ and blood vessels to maintain continuous blood circulation. Among blood vessels, arteries form distribution network to capillaries which are the main sites of interchange of gases and metabolites between body tissue and blood. Veins return blood from capillaries to the heart. There is another vascular system known as lymph vascular system. It is a passive drainage system for returning excessive extravascular fluid, the lymph, to the blood vascular system without intrinsic pumping mechanism. A term circulatory system is used to cover both vascular systems. The term cardiovascular system used here is to focus on histological features of heart, arteries, veins, and capillaries, but lymphatic vessels are also discussed.
Heart
Human heart has four cardiac chambers, two atria and two ventricles. The walls of ventricles are thicker than those of atria. Despite the thickness, both chambers possess common histological features. They are composed of three layers: epicardium, myocardium, and endocardium.
Atrial Wall
A section of cardiac wall is cut through the atrial wall and stained by HE (Fig. 8-1). It reveals three layered wall structure composed of epicardium (Ep), myocardium (My), and endocardium (En). There is a cardiac vessel (CV) seen within the layer of myocardium (Fig. 8-2). The innermost endothelium (En) is composed of a simple squamous endothelium (SQE) and subendothelial fibroelastic connective tissue (Fe). It is continuous with the adjacent myocardium (My).
In the myocardium, cardiac muscle fibers form in bundles being sectioned longitudinally (L), transversely (T), and obliquely (O) respectively (Fig. 8-4). Different muscle bundles are separated by fibrous connective tissue (FC). The arrangement of complex, three-dimensional network allows the heart to contract in multiple directions simultaneously for maximum blood expulsion. The outermost epicardium (Fig. 8-5) is covered by a simple squamous mesothelium (SQM) deep to which is fibroelastic connective tissue (Fe). Nerves (N) and blood vessels (BV) can be found in the epicardium (Fig. 8-6).
Note: Detailed histological structure of cardiac muscle and connective tissue, please go back to the chapters Muscular Tissue and Connective Tissue for review.
Ventricular Wall
Histological structure of the ventricle has not much difference from that of the atrium except the thickness (Fig. 8-7). The ventricular wall is also composed of epicardium (Ep), myocardium (My), and endocardium (En). Inside the chamber cavity (CV), there are sections of three papillary muscles (PM). As seen in the section of atrium, the innermost endothelium (En) of ventricle is composed of a simple squamous endothelium (SQE) and subendothelial fibroelastic connective tissue (Fe), which is continuous with the adjacent myocardium (My).
The thick myocardium also has the arrangement of complex, three-dimensional network. Muscle fibers are seen to be sectioned longitudinally (L), transversely (T), and obliquely (O) respectively (Fig. 8-9). Similar to that of atrial wall, the outermost epicardium of the ventricle (Fig. 8-10) is covered by a simple squamous mesothelium (SQM). Between mesothelium and myocardium (My) is fibroelastic connective tissue.
At certain sites underneath the endocardium (En), there are swollen cells with pale stained cytoplasm (Fig. 8-11). These cells are not found in the atrial wall. They are Purkinje fibers (P), a group of specialized cardiac muscle cells that form a network in the inner walls of the ventricles between endocardium (En) and myocardium (My). Some Purkinje fibers can be found in the myocardium near the endocardium (Fig. 8-12), at base of papillary muscle (PM) or even extend into the papillary muscle (Fig. 8-13). Purkinje fibers (P) can be distinguished from common cardiac muscle cells (C) by their pale cytoplasm. They have relatively few myofibrils arranged in an irregular manner immediately underneath the cell membrane (Fig. 8-14). Neither striations nor intercalated discs are formed in the Purkinje fibers. It has been proved that Purkinje fibers are involved with coordinated contraction of the entire ventricular myocardium to pump blood.
Purkinje fibers (P) are also found in between common cardiac muscle layers (Figs. 8-15, 8-16, 8-17, 8-18). Adipose tissue (Ad) is seen to be associated with the presence of Purkinje fibers (Figs. 8-15, 8-17, 8-18). Blood vessel (BV) can also be found (Fig. 8-17).
As stated above, Purkinje fibers (P) are not only found at the base of papillary muscle (Fig. 8-13) but also found to extend into the papillary muscles (Figs. 8-19 and 8-20). To explain the involvement of Purkinje cells in blood circulation, it is necessary to know about the function of papillary muscles. In a coronally bisected heart (Fig. 8-21), one atrium and 2 ventricles are exposed to show the interiority of right atrium (RA), right ventricle (RV), and left ventricle (LV). The connection between inferior vena cava (IVC) and right atrium is also exposed. Interventricular septum (IVS) is located between two ventricles. Each ventricle has papillary muscles (PMR, PML), which are pillar-like muscles projecting from ventricular wall and sending out cord-like structures called chordae tendineae (CT) to connect with atrioventricular valves (AV). The main function of papillary muscle is to contract during ventricular systole (contraction) to prevent the atrioventricular valves from opening backward into the atria. It has been proven that Purkinje fibers are formed from branching of the bundle of His and then distribute into ventricular wall. The bundle of His helps in transmitting electrical impulse from the primary pacemaker sinoatrial node (SA node) to the ventricles. Then, Purkinje fibers may cause contraction of the ventricular muscles to eject blood out into the circulation, and simultaneously to prevent backflow though action of papillary muscles on atrioventricular valves. Furthermore, Purkinje fiber may also act as an alternative pacemaker when the SA node fails to generate impulse.
Note: At this moment, the name of “Purkinje” has appeared twice. One is “Purkinje cell” of the cerebellum in the chapter NERVOUS TISSUE. The other is “Purkinje fiber” of the hear here. Both terms are named after Czech physiologist Jan Evangelista Purkyně who identified Purkinje cell in 1837 and Purkinje fiber in 1839.
Heart Valves
There are four kinds of valves in heart, including aortic valve between left ventricle and aorta, mitral valve between left ventricle and left atrium, pulmonary valve between right ventricle and pulmonary trunk, and tricuspid valve between right ventricle and right atrium. The mitral valve is bicuspid, i.e., having two leaflets. Other three valves are tricuspid, i.e., having three leaflets.
In a longitudinal section of the aortic valve (Fig. 8-22), either aortic side (Fig. 8-23) or ventricular side (Fig. 8-24) of the valve is covered by a layer of endothelial cells (EC). Underneath the layer of endothelial cells, fibrous connective tissue with fibroblasts can be seen.
The core of the aortic valve is composed of different kinds of interstitial cells (Figs. 8-25, 8-26). It has been suggested that these interstitial cells include smooth muscle cells, fibroblasts, and myofibroblasts.
In a longitudinal section of mitral valve between left ventricle and left atrium (Fig. 8-27), ventricular side and atrial side can be judged by the attachment of chordae tendineae (CT) on the valve and the presence of Purkinje fibers (arrow) underneath the endocardium of the ventricular wall (VW). Similar to the aortic valve mentioned above, either atrial side (Fig. 8-28) or ventricular side (Fig. 8-29) of the valve is covered by a layer of endothelial cells (EC). Underneath the layer of endothelial cells, fibrous connective tissue can be seen.
The core tissue of the mitral valve can be divided into three regions by the criteria of connective tissue (Fig. 8-30) : dense irregular connective tissue (A); loss connective tissue (B); dense regular connective tissue (C). Except the C-region (Fig. 8-33), both A-region (Fig. 8-31) and B-region (Fig. 8-32) contain cells other than fibroblasts. The composition of the C-region is very similar to that of ligament or tendon.
To observe histological composition of the chordae tendineae, micrographs are taken from three spots (Fig. 8-34): A. longitudinal section of an attached segment on the mitral valve (Fig. 8-35); B. longitudinal section of a terminal segment unattached on the valve (Fig. 8-36); C. transverse section of a free segment (Fig. 8-37).
All three segments of chordae tendineae are encapsulated by a layer of endothelial cells. The attached segment (Fig. 8-35) is composed of dense regular connective tissue (DR) in the middle surrounded by loss connective tissue (LC) and dense irregular connective tissue (DI). The free segment (Fig. 8-36) is composed of dense regular connective tissue only, which is similar to composition of ligament. The unattached terminal segment (Fig. 8-37) shows a central core (C) surrounded by layers of circular fibrous connective tissue.
Tricuspid valve is located between right ventricle and right atrium. In a section of the valve (Fig. 8-38), ventricular side and atrial side can be judged by the presence of chordae tendineae (CT) and their attachments (arrow) on the valve leaflet. Both ventricular side (Fig. 8-39) and atrial side (Fig. 8-40) of the valve leaflet are covered by a layer of endothelial cells (EC). Underneath the layer of endothelial cells, fibrous connective tissue can be seen.
The core tissue of the tricuspid valve is composed of fibrous connective tissue which may have different arrangement of collagenous fibers and elastic fibers. In one part of the valve(Fig. 8-41), dense collagenous fibers (D) are seen in the middle surrounded by loose connective tissue (L). In other part of the valve (Fig. 8-42), loose connective tissue (L) is seen nearing the ventricular side (VS) while dense connective tissue (D) is seen nearing the atrial side (AS). At the sites for the attachment of chordae tendineae (arrow), dense collagenous fibers (D) is found to aggregate underneath the layer of endothelial cells (Fig. 8-43).
Each of the two attachments of chordae tendineae (arrow) show a mass of dense collagenous fibers (D) surrounded by loose connective tissue (Fig. 8-44). These two masses seem to originate from dense connective tissue (D) underneath the endothelial layer at ventricular side (VS). Sections of three adjacent chordae tendineae feature a layered structure consisting of a central core of dense collagen fibers (D), an outer layer of elastic fibers interwoven with loose collagen, and a single layer of endothelial cells covering the exterior (Figs. 8-45, 8-46)).
Arteries
Arteries can be classified into three types: elastic arteries, muscular arteries, and arterioles in terms of their sizes and wall structures. Arterial wall is composed of three layers: tunica Intima, tunica media, and tunica adventitia. Composition of each layer is various among three types of arteries.
Elastic Arteries
Elastic arteries are the largest ones which arise directly from the heart, including aorta, pulmonary arteries, brachiocephalic artery, common carotid arteries, subclavian arteries, and common iliac arteries. Here we use aorta as an example to illustrate their wall structures. In a transverse section of aorta stained by HE (Fig. 47), clear cut layers of tunica Intima (TI), tunica media (TM), tunica adventitia (TA), and junctional area between tunica media and tunica adventitia, known as external elastic lamina (EEL). Adipose tissue (Ad), nerve bundles (N), and vessel are found in the tunica adventitia. The vessel is called vasa vasorum (VV), which is a nourish vessel for the aorta. The tunica Intima (TI) is composed of a single layer of endothelial cells (EC) and a supporting layer of collagenous tissue in form of both fibers and discontinuous sheets (Fig. 8-48). It can be differentiated from the tunica media (TM) by staining. Fibroblasts (F) and myointimal cells (Mi) can be found in this layer of collagenous tissue. Myointimal cells are smooth muscle cells located in the tunica Intima of blood vessels, between the endothelial lining and the internal elastic lamina. They can proliferate to form a thickened layer of tissue called myointimal hyperplasia, which can lead to vessel stenosis.
The tunica media is particularly broad and extremely elastic. It consists of few smooth muscle cells (SM) attached to concentric fenestrated membranes (FM) formed by elastic fibers, which can not be distinguished from collagen fibers by HE staining (Fig. 8-49). As shown in Fig. 8-47, between tunica media and tunica adventitia there is a thick layer, known as external elastic lamina (EEL). It is composed of elastic connective tissue (Fig. 8-50), similar to that of the ligament (Figs. 3-25, 3-26 in the chapter of Connective Tissue). The tunica adventitia consists of collagenous connective tissue with some elastic fibers (Fig. 8-51).
To identify the presence of elastic tissue in the wall of aorta, a transverse section stained by RF (Fig. 8-52) is observed. As seen in Fig. 47, three-layered wall structure, such as tunica Intima (TI), tunica media (TM), and tunica adventitia (TA), can be distinguished clearly. The elastic staining reveals two junctional layers: internal elastic lamina (IEL) and external elastic lamina (EEL). At high magnification (Fig. 8-53), it is shown that the tunica Intima is composed of a single layer of endothelial cells (arrow) and underneath collagenous tissue which is stained brick red color. Elastic fibers and cell nuclei are stained black.
As shown in Fig. 8-54, the internal elastic lamina (IEL) is a junctional layer between tunica Intima (TI) and tunica media (TM). It can be divided into upper and lower two parts in terms of amount of elastic fibers and collagenous fibers (Fig. 8-55). The upper part has more elastic fibers (stained black). In contrast, the lower part has fewer elastic fibers but more collagenous fibers (stained brick red). The tunica media can also be divided into two parts. The upper part starts form the outer limit (arrow) of the internal elastic lamina (Fig. 8-56). It contains elastic fibers (stained black) elastic fibers (stained black), collagenous fibers (stained brick red), and smooth muscle cells which are mixed up with collagenous fibers. Most of elastic fibers are straight. The lower part also contains elastic fibers (stained black), collagenous fibers (stained brick red), and smooth muscle cells (Fig. 8-57). Most elastic fibers are curves (arrow). Fenestrations can be seen in both parts. The lower part seems to be the external elastic lamina (EEL) seen in Fig. 8-50.
The tunica adventitia is composed of collagenous connective tissue stained red and elastic fibers stained black (Fig. 8-58). In comparison with the external elastic lamina (EEL), elastic fibers are relatively few (Fig. 8-59). Vasa vasorum (VV) and nerve bundles can be seen in the tunica adventitia.
In a transverse section of aorta stained for elastic fibers (Fig. 8-60), tunica intima (TI), tunica medium (TM), and tunica adventitia (TA) are seen clearly separated by internal elastic lamina (IEL) and external elastic lamina (EEL). Vasa vasorum (VV) can be seen in the tunica adventitia. There is an eminence (four-pointed star) projected by tunica intima (TI). Apparently, it is intimal hyperplasia. To avoid observing possible abnormality, the following micrographs (Figs. 8-92 and 8-63)are taken from areas distant from eminence at high magnification. It shows that except the internal elastic lamina (IEL) few elastic fibers also appear in tunica intima (TI) and tunica medium (TM). External elastic lamina (EEL) is wider than internal elastic lamina. Its elastic fibers extend into tunica adventitia (TA). Tunica medium (TM) has few elastic fibers. Longitudinal oriented smooth muscle fibers (LSM) are found to aggregate in bundles in tunica adventitia.
Note: Intimal hyperplasia is the thickening of the inner layer of a blood vessel wall, caused by the migration and proliferation of smooth muscle cells in response to injury.
Muscular Arteries
Muscular arteries are branches of elastic arteries or branches of muscular arteries. They are named arteries in addition to those elastic arteries stated above. In a transverse section of large artery (Fig. 8-63), it has typical features of a muscular artery, such as thin tunica Intima (TI), thicker tunica media (TM), and tunica adventitia (TA) containing vasa vasorum (VV). The tunica Intima is composed of endothelium (E) and a thin layer of subendothelial connective tissue where collagenous fibers and few longitudinally oriented smooth muscle fibers (Fig. 8-64). Internal elastic lamina is (IEL) visible and can be distinguished from the tunica media (TM) which contain many layers of circumferential smooth muscle fibers mingled with elastic, reticular, and collagenous fibers (Fig. 8-65). These fibers cannot be differentiated in HE stained section. External elastic lamina (EEL) is present between tunica media (TM) and tunica adventitia (TA) which is composed of collagenous and elastic tissue (Fig. 8-66). Some smooth muscle fibers may also be found in the tunica adventitia.
In a transverse section of medium artery, it shows typical feature of a typical muscular artery even though its lumen diameter is only about 2 mm (Fig. 8-67). Arterial wall is also composed of tunica Intima (TI), tunica media (TM), and tunica adventitia (TA). Both internal elastic lamina (IEL) and external elastic lamina (EEL) are visible. The tunica Intima is covered by a single layer of endothelial cells (EC), which project into the lumen (Fig. 8-68). Underneath the endothelial layer, there is a relatively thin layer of fibrous connective tissue (FC). The internal elastic lamina (IEL) is also thin and contains only 2-3 curved elastic fiber bundles. Although the tunica media (TM) is also composed of fenestrated elastic membranes and smooth muscle fibers (SM), the amount of smooth muscle fibers is much more than that of elastic artery (Figs. 8-69, 8-70).
The external elastic lamina (EEL) of this medium artery is distinguishable from the tunica media (TM) above and tunica adventitia (TA) below (Fig. 8-68). It is composed of sheets of elastic connective tissue (Fig. 8-69). Many curved elastic fiber bundles (arrow) can be seen. As seen in the elastic artery above, the tunica adventitia (TA) of muscular artery (Fig. 8-70) is also composed of collagenous connective tissue containing vessels (V) and nerve bundles (N). Some longitudinally oriented smooth muscle fibers (SM) can be found.
Arterioles
An arteriole is the smallest division of the arterial network, connecting arteries to capillary beds. Although all three layers such as tunica Intima, tunica media, and tunica adventitia are visible, the wall of an arteriole contains only 1-5 layers of smooth muscle fibers in the tunica media. By this criterion, many ambiguously defined “small arteries” are not necessarily arterioles. For example, in a section of adipose tissue stained by HE (Fig. 8-74), the original targets are small artery (A) and small vein (V) but neither of them is arteriole. Many smaller ones could be. Using the labeled small artery as a center, two arterioles can be found at the direction between four and five o’clock (Figs. 8-75 and 8-76). Both of them consist of single layer of endothelial cells (EC) with relatively few supporting tissue in tunica Intima and at least three layers of smooth muscle fibers (SM) in tunica media. Outside the smooth muscle fibers there is a thin layer of tunica adventitia with visible fibroblasts (F). A layer of zig-zag red line is seen between tunica intima and tunica medium. It is internal elastic lamina (IEL).
There are many arterioles that can be found in the same tissue section. In Fig.8-77, an arteriole (Ar) having two layers of smooth muscle fibers is found with a venule (Vn) is seen. In Fig. 8-78, an arteriole (Ar) having only layer of smooth muscle fiber with a capillary (C) is seen. In Fig. 8-79, two arterioles (Ar) are seen with a venule (Vn). The internal elastic lamina (IEL) can be seen as zig-zag red lines seen between tunica intima and tunica medium of both arterioles. Histology structures of venule and capillary are described later in this chapter.
Capillaries
As terminal ends of arterial blood supply, many capillaries are distributed to form capillary network within tissues and organs. In a section of adipose tissue (Fig. 8-80), not only small arteries (A), small veins (V), and nerve bundles (N) are seen, but also capillaries can be found. A capillary is found in the stroma of the adipose tissue (Fig. 8-81). Transverse section of the capillary reveals the wall composition of a single endothelial layer (En). Nucleus of an adipocyte (Ad) is next to it. Longitudinal section of a capillary (Fig. 8-82) also clearly shows the wall structure of a single endothelial layer. In one larger stomal area (Fig. 8-83), two capillaries (C), one arteriole (Ar), and two nerve bundles (N) are found. To distinguish capillary from arteriole is mainly based on the existence of smooth muscle fibers (SM) outside the endothelial layer (En) of the arteriole.
There are three main types of capillaries: 1) continuous capillaries have an uninterrupted wall and are found in the skin, muscles, and brain; 2) fenestrated capillaries have pores on wall and are located in the kidneys, intestines, and glands to allow for more exchange of molecules; 3) sinusoidal capillaries, also known as discontinuous capillaries, have the largest gaps, allowing large molecules and even blood cells to pass through, and are found in the liver, bone marrow, and spleen. Thery cannot be distinguished under the light microscope. For detailed information, please check on you textbook.
Veins
In blood circulation, oxygen carrying arteries form capillary network at the end. After gas exchange within tissue, the capillary network connects with carbon dioxide carrying veins to start blood drainage into venous system. In both tissue sections above (Figs. 8-74 and 8-80), anatomical connection from arteriole (Ar) to capillary (C), then to venule (Vn), which is the smallest vein, can be observed from two figures below (Figs. 8-84 and 8-85). Note that there are three locations (arrow) showing transverse section of capillary mixed within longitudinal sections (C) of capillaries. It indicates the formation of capillary network. Either venule (V) has much larger lumen and thinner wall than the arteriole (Ar) next to it. Both venules are also known as post-capillary venules. The tunica intima of a post-capillary venules consists of endothelium (En) on a very thin subendothelial connective tissue layer (Fig. 8-86). Pericytes (P) can be seen to be with endothelial cells. The tunica medium of this small venule is very thin or absent, while the tunica adventitia is thick and consists of collagenous connective tissue.
Two large venules or medium-sized veins are observed (Figs. 8-87 and 8-88). One of them is found to have small venules (Vn) draining into its lumen (Fig. 8-88). Both of them have thicker wall by increasing the thickness of tunica medium (TM) and tunica adventitia (TA), but not tunica intima (TI). The tunica intima is composed of a single layer of endothelial cells (EC) and a scan amount of subendothelial connective tissue (Fig. 8-89). The tunica medium (TM) consists of a few layers of smooth muscle fibers. Some of the muscle fibers may be longitudinally disposed instead of being circularly disposed. The tunica adventitia (TA) is composed of collagenous connective tissue with few elastic fibers. Vessel thickness is mainly contributed by the tunica adventitia.
A transverse section of large vein stained by HE (Fig. 8-90), which is labeled as “Medium Vein” in DSMH, is observed. It is also composed of tunica Intima (TI), tunica media (TM), and tunica adventitia (TA) as seen in smaller veins, but has thicker subendothelial connective tissue layer (Fig. 8-91). Circular smooth muscle fibers appear to be interspersed among collagenous connective tissue In tunica media. The tunica adventitia is much thicker and contains many longitudinally oriented smooth muscle fiber bundles (LSM) among collagenous connective tissue with elastic fibers. Vasa vasorum (VV) are also seen.
For comparison, a transverse section of the other large vein stained by HE (Fig. 8-92), which is labeled as “Large Vein” in DSMH, is also observed. Vasa vasorum (VV) are seen in tunica adventitia. This vein has thin tunica Intima (TI) as seen in the above vein, but thicker tunica media (TM) and tunica adventitia (TA) than those of the above vein due to increase of smooth muscle fibers in both tunica media and tunica adventitia (Fig. 8-93). The smooth muscle fibers are circularly oriented in tunica media (TM) but longitudinally oriented in bundles (LSM) in tunica adventitia (TA). Elastic fibers can be found to be dispersed among smooth muscle fibers in tunica media (TM). More elastic fibers and even a band of elastic tissue (ET) are seen between tunica media (TM) and tunica adventitia (TA).
Vena Cava
The vena cava, including superior vena cava and inferior vena cava, is the largest vein in human body. Transverse section of a vena cava (Fig. 8-94) shows that there are many eminences (four-pointed stars) from tunica intima (TI). Apparently, this is a vena cava with intimal hyperplasia. Compared with the above two large veins, it has a thicker tunica media (TM) and thinner tunica adventitia (TA). Vasa vasorum (VV) are seen in tunica adventitia. To avoid observing possible abnormality, it is focused on a spot without eminence (blue circled) at high magnification (Fig. 8-95). It shows that the tunica intima (TI) is composed of a single layer of endothelium with a thin layer of fibrous connective tissue. No layer of elastic tissue is found between tunic intima and tunica medium (TM). The tunica medium consists of smooth muscle fibers and wavy sheets of elastic fibers, which are not stained clearly by HE (Fig. 8-96). Most smooth muscle fibers are oriented circumferentially (CSM), but some are longitudinally oriented (LSM).
Note: Intimal hyperplasia is the thickening of the inner layer of a blood vessel wall, caused by the migration and proliferation of smooth muscle cells in response to injury.
Focusing on the spots of tunica medium (TM) closing to tunica adventitia (TA) at high magnification, more longitudinally oriented smooth muscle fibers (LSM) can be found (Figs. 8-97 and 8-98). The tunica adventitia (Fig. 8-99) is composed of dense irregular connective tissue with adipose tissue (Ad). Two vasa vasorum (VV) are seen penetrating into the tunica medium (TM).
To know if the elastic fibers are present in the wall of vena cava, a section stained by VE is observed (Fig. 8-100). The section cut through partial atrium and shows atrial chamber (AC) and cardiac ganglion (CG) attached to the atrial wall. Lumen (L) of the superior vena cava (SVA) can be recognized. Tunica medium (TM) is thick, instead both tunica intima (TI) and tunica adventitia (TA) are thin (Fig. 8-101). In the tunica intima (Fig. 8-102), supporting connective tissue underneath the endothelium is mainly composed of fibrous collagenous tissue with few elastic fibers (EF).
In tunica medium of the vena cava (Fig. 8-103), it is found that most smooth muscle fibers are cross sectioned and packed in bundles. As stated above (Figs. 8-96), most smooth muscle fibers in tunica medium are oriented circumferentially (CSM), the appearance of cross sections indicates that the vena cava is sectioned longitudinally along its length. Spaces among muscle bundle are filled with collagenous tissue (brick red) with few elastic fibers (black). In tunica adventitia (TA), while smooth muscle fibers in tunica medium are oriented circumferentially (CSM), here they are oriented longitudinally (LSM) with collagenous tissue and elastic fibers (Fig. 8-104). Vasa vasorum (VV), nerve bundles (N), and adipose tissue (Ad) can also be found (Fig. 8-105).
Lymphatic Vessels
Lymphatic vessels are the components of the lymph vascular system and form a network of thin tubes that collect a watery fluid called lymph from body tissues and return it to the bloodstream. Since lymphatic vessels filter lymph through lymph nodes, it is convenient to use section of the lymph node for observing histological structure of the lymphatic vessel.
In a section of human lymph node stained by HE, two lymphatic vessels are found to run side by side (Fig. 8-106). Both of them have thin layer of endothelium (En). Many lymphocytes (Ly) can be seen in lumens of the lymphatic vessels.
One micrograph taken from the same section of lymph node (Fig. 8-107) shows two lymphatic vessels composed of thin endothelium (En) with lymphocytes (Ly) in the lumens. Inside the lymph node, there is a chance to see three lymphatic vessels (1, 2, 3), composed of thin endothelial layer (En), converging together (Fig. 8-108).
The other micrograph (Fig. 8-109) shows that Inside the lumen of a lymphatic vessel, lymphatic valve (LV) is seen to extend from endothelium (En). Many lymphocytes (Ly) are found inside the lumen. Micrograph taken from a section of mammalian lymph node shows two lymphatic vessels in the hilum (Fig. 8-110). In the lumens of both lymphatic vessels, lymphatic valves (LV) are found. Similar to those in veins, lymphatic vessels have one-way lymphatic valves, to ensure that lymph flows in a single direction back toward the heart.
NOTE:
- Only those organelles visible under the light microscope are discussed here. It is suggested that to study all organelles visible under the electron microscope through your histology textbook and atlas.
- All photos used for discussion are taken from DSMH, DSAH digital slides and other source as follows:
H060020 Atrial Wall, sec., human, HE. (Figs. 8-1, 8-2, 8-3, 8-4, 8-5, 8-6)
H060030 Ventricular Wall, sec., human, HE. (Figs. 8-7, 8-8, 8-9, 8-10, 8-11, 8-12, 8-13, 8-14, 8-15, 8-16, 8-17, 8-18, 8-19, 8-20)
H060050 Aortic Valve, ls. of semilunar valve, human, HE. (Figs. 8-22, 8-23, 8-24, 8-25, 8-26)
H060060 Mitral Valve, ls. of bicuspid valve, human, HE. (Figs. 8-27, 8-28, 8-29, 8-30, 8-31, 8-32, 8-33, 8-34, 8-35, 8-36, 8-37)
H060070 Tricuspid valve, ls., human, HE. (Figs. 8-38, 8-39, 8-40, 8-41, 8-42, 8-43, 8-44, 8-45, 8-46)
H060080 Aorta, cs., human, HE. (Figs. 8-47, 8-48, 8-49, 8-50, 8-51)
H060081 Aorta, cs., human, VE. (Figs. 8-52, 8-53, 8-54, 8-55, 8-56, 8-57, 8-58, 8-59)
H060091 Aorta and Vena Cava, cs., human, VE. (Figs. 8-100, 9-101, 8-102, 9-103, 9-104, 9-105)
H060101 Medium Artery, cs., human, HE. (Figs. 8-67, 8-68, 8-69, 8-70, 8-71, 8-72, 8-73)
H060102 Medium Vein, cs., human, HE. (Figs. 8-90, 8-91)
H060110 Large Artery, cs., human, HE. (Figs. 8-63, 8-64, 8-65, 8-66)
H060120 Large Vein, cs., human, HE. (Figs. 8-92, 8-93)
H060122 Vena Cava, cs., human, HE. (Figs. 8-94, 8-95, 8-96, 8-97, 8-98, 8-99)
H060130 Capillaries, sec., human, HE. ((Figs. 8-80, 8-83, 8-84, 8-85, 8-86, 8-87)
H060140 Small Artery and Vein, cs., human, HE. (Figs. 8-74, 8-75, 8-76, 8-77, 8-78, 8-79, 8-81, 8-82, 8-88, 8-89)
H070010 Lymph Node, sec., human, HE. (Figs. 8-106, 8-107, 8-108, 8-109)
H070011 Lymph Node, sec. through hilum, mammal, HE. (Figs. 8-110)
Ho1762e Aorta, human, t.s. stained for elastic fibers. (Figs. 8-60, 8-61, 8-62) - Staining methods and results:
HE = hematoxylin and eosin, is used to stain cell nuclei blue and cytoplasm pink or red. Hematoxylin may also stain ribosomes and rough endoplasmic reticulum blue.
VE = Verhoeff’s elastic stain, is used to stain elastic fibers and cell nuclei black, collagen fibers red, and other tissue elements yellow.